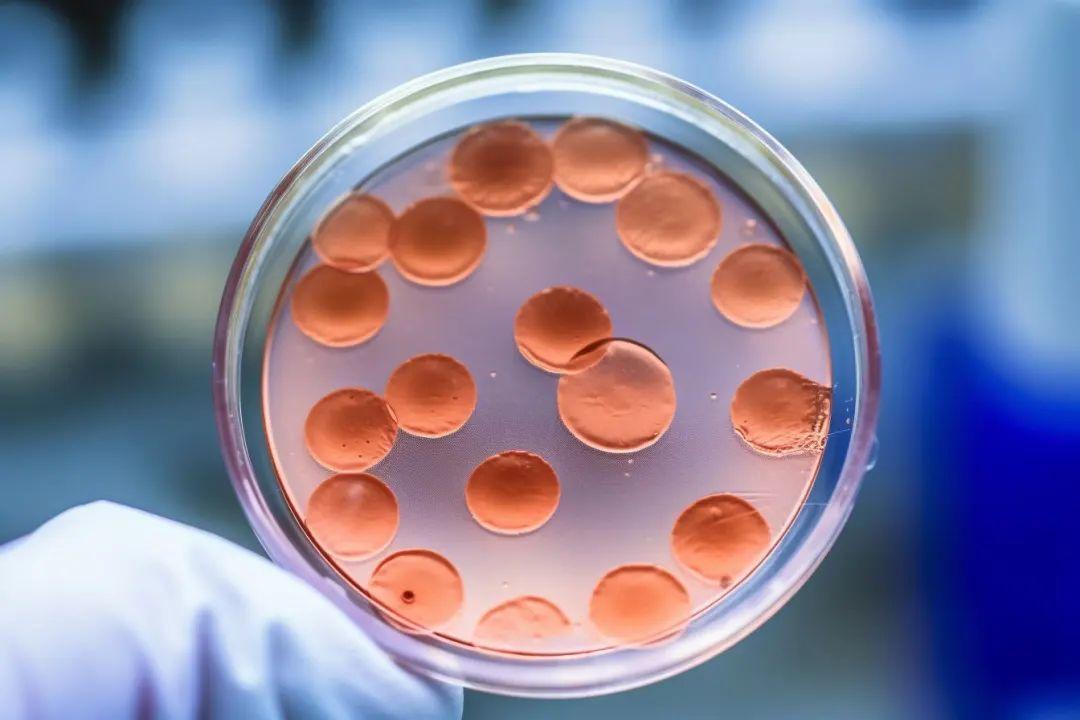
研究显示新技术可快速检测细菌耐药性

研究显示新技术可快速检测细菌耐药性
作者:小微
发表于:2026年03月23日
浏览量:52315
图片来源于网络,如有侵权,请联系删除
新华社赫尔辛基3月23日电(记者朱昊晨 徐谦)斯德哥尔摩消息:瑞典卡罗琳医学院日前发布新闻公报说,该院研究人员开发出一种快速、低成本的检测细菌耐药性技术,有望帮助临床医生更早作出用药判断。
公报说,传统检测通常需要先培养细菌,再观察菌群在抗生素作用下是否继续生长,往往耗时较长。而这项名为s5PSeq的检测技术,可检测细菌在接触抗生素后其核糖核酸出现的分子反应,因此无需等到菌群出现可见的生长差异,就能判断出细菌对药物是敏感还是耐药。

图片来源于网络,如有侵权,请联系删除
实验显示,在用红霉素处理艰难梭菌仅10分钟后,这项技术就能够区分对红霉素耐药或敏感的菌株。
这项技术的另一优点是与便携式纳米孔测序设备兼容。这类设备目前已在许多医疗诊断和科研实验室应用,因此该技术有望较方便地纳入常规临床检测流程。
研究人员表示,快速检测对于有效应对抗生素耐药性十分关键,在过去的医疗诊断流程中,有时需要数天才能获得检测结果,新技术有望将这个时间大大缩短,接下来将评估该技术在真实临床环境中的应用潜力。
相关研究成果已发表于美国学术期刊《细胞报告·方法》。
【责任编辑:吴京泽】